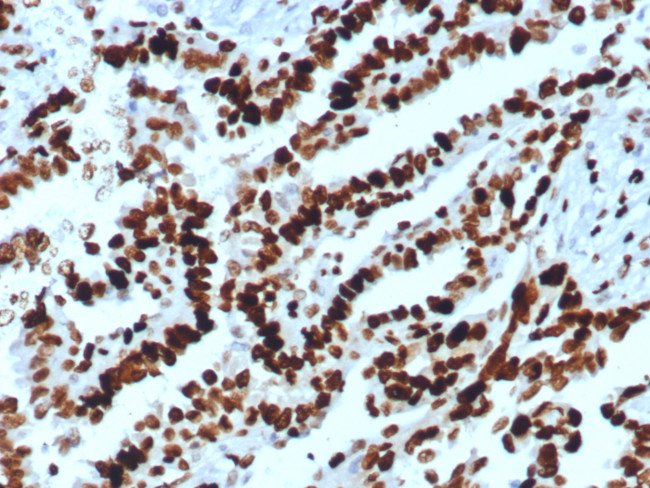
MCM2 (Proliferation Marker) Antibody in Immunohistochemistry (Paraffin) (IHC (P))

Search
NeoBiotechnologies
MCM2 (Proliferation Marker) Recombinant Rabbit Monoclonal Antibody (MCM2/8006R)
{{$productOrderCtrl.translations['antibody.pdp.commerceCard.promotion.promotions']}}
{{$productOrderCtrl.translations['antibody.pdp.commerceCard.promotion.viewpromo']}}
{{$productOrderCtrl.translations['antibody.pdp.commerceCard.promotion.promocode']}}: {{promo.promoCode}} {{promo.promoTitle}} {{promo.promoDescription}}. {{$productOrderCtrl.translations['antibody.pdp.commerceCard.promotion.learnmore']}}
产品信息
4171-RBM5-P0
种属反应
宿主/亚型
Expression System
分类
类型
克隆号
抗原
偶联物
形式
浓度
规格
纯化类型
保存液
内含物
保存条件
运输条件
靶标信息
MCM2 (Mini chromosome maintenance protein 2) is involved in regulating DNA replication. MCM2 (also called CDCL1, mitotin and BM28), is a human nuclear protein that is crucial in the cell cycle, being involved in the onset of DNA replication and cell division. It is similar to members of the family of early S-phase proteins. MCM2 has been mapped to 3q21. From its localization, CDCL1 became a candidate for an oncogene affected by chromosomal breaks in acute myeloid leukemia (AML).
仅用于科研。不用于诊断过程。未经明确授权不得转售。
篇参考文献 (0)
生物信息学
蛋白别名: cell devision cycle-like 1; cyclin-like 1; DNA replication licensing factor MCM2; KIAA0030; MGC10606; minichromosome maintenance deficient 2 (mitotin); Minichromosome maintenance protein 2 homolog; Nuclear protein BM28; unnamed protein product
基因别名: BM28; CCNL1; cdc19; CDCL1; D3S3194; DFNA70; KIAA0030; MCM2; MITOTIN
UniProt ID: (Human) P49736
Entrez Gene ID: (Human) 4171